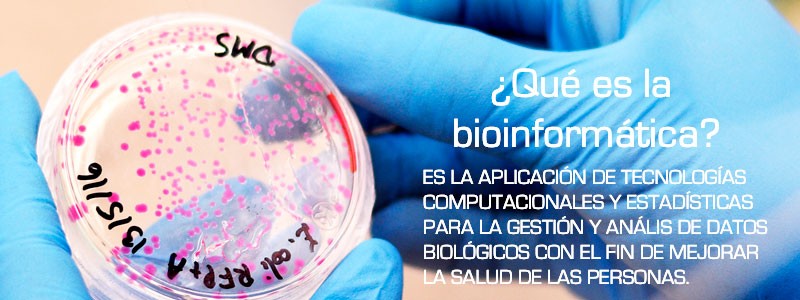

Costa Rica impulsa bioinformática con articulación nacional
- Consejo Técnico de Bioinformática Clínica promueve proyectos de salud para enfrentar enfermedades de origen molecular.

Imagen ilustrativa. (Fotografía: Archivo TEC)
Promover e impulsar proyectos que mejoren la prevención de enfermedades mediante el análisis genómico y lograr la detección temprana de las mismas es parte del objetivo que se ha propuesto el país en el contexto salud.
Por eso, la creación del Consejo Técnico Nacional de Bioinformática Clínica se convirtió en uno de los pasos más importantes de esta materia para Costa Rica, ya que a partir de este, diversas instituciones, universidades y otros organismos se han articulado para fomentar la investigación, actividad académica y formación profesional en este campo.
Creado mediante decreto del Ministerio de Ciencia, Tecnología y Telecomunicaciones (Micitt) y coordinado por el Ministerio de Salud, el Consejo es un ente que apoya la promoción de proyectos de salud que requieran el análisis de datos e información de genes como el ADN y el ARN.
Diversas instituciones son las que conforman el Consejo, entre ellas el TEC mediante la Escuela de Biología, quien en conjunto con la Universidad de Costa Rica (UCR), la Universidad Nacional (UNA), y el Centro Nacional de Alta Tecnología (CeNAT), buscan articular conocimiento, profesionales, instalaciones y experiencias en la bioinformática clínica nacional.
Además, son parte el Hospital San Juan de Dios, el Hospital Nacional de Niños, así como el Servicio Nacional de Salud Animal (SENASA) y la Asociación de Biotecnología, Dispositivos Médicos y Sectores Afines a las Ciencias de la Vida (CR-biomed).
Para la ingeniera Karol Jiménez, representante del TEC en este Consejo, estar justamente en este organismo demuestra las capacidades que tiene la Institución en el área bioinformática, al tiempo que presenta oportunidades como la posibilidad futura de adquir nuevos equipos de investigación como lo es un secuenciador de ADN, el cual logre potenciar esta área y otras investigaciones del contexto biotecnológico.
"El TEC realiza un trabajo fuerte y destacado que marcan cómo la salud es un campo de atención prioritario, a pesar de no tener carreras enfocadas directamente a esta área". Ing. Karol Jiménez, representante del TEC.
Hacia la medicina de precisión molecular
Como parte de las actividades que impulsa este Consejo, este 24 y 25 de octubre, en el Hospital San Juan de Dios, se realizará la I Jornada de Bioinformática Clínica, el cual tendrá como punto de discusión principal el camino de la medicina de precisión molecular.
El encuentro será justamente en el Hospital San Juan de Dios, ya que son los profesionales en salud (médicos, enfermeras, nutricionistas, entre otros) los que podrán asistir a este evento impulsado por el Consejo y sus instituciones representantes.
La actividad, responde según comentó Jimenez, a un plan de acciones que está desarrollando el Consejo durante este 2019 y el 2020, en el que se realizarán diversas actividades como talleres, encuentros y otros que buscarán afianzar más el papel bioinformático en el país y cumplir con lo estipulado en el Reglamento para la creación y funcionamiento del Consejo Técnico de Bioinformática Clínica.
En la jornada, el TEC presentará la ponencia: Desarrollo de biosensores para diagnóstico de enfermedades y agentes infecciosos: Cáncer de próstata y Clostridium difficile, la cual será expuesta por Jiménez y el ingeniero David García, miembro suplente de este Consejo.
La Jornada es un complemento del Consejo con el fin de impulsar la Red Nacional de Secuenciación Genómica y Supercomputación, la cual busca avanzar en el proyecto genómico nacional y prever formas futuras de satisfacer necesidades en torno a la medicina de precisión y clínica nacional.
